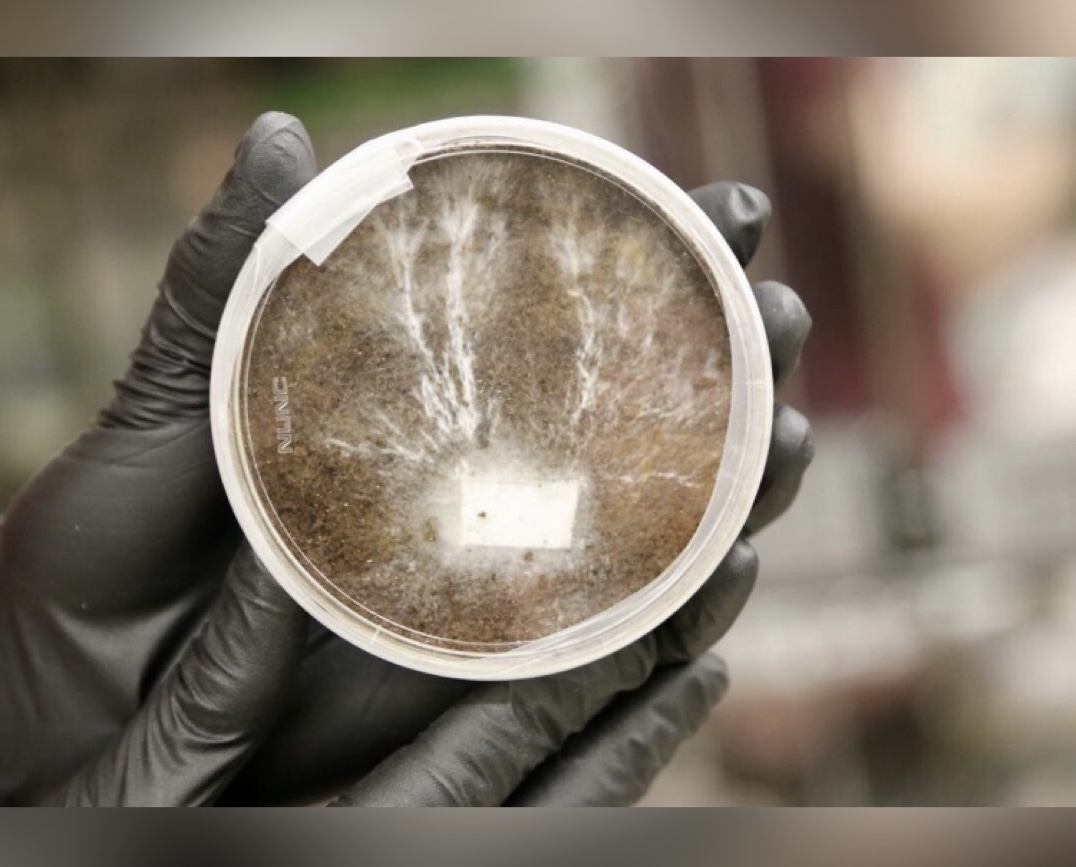

NASA의 Mycelium 소재가 건설 혁명을 일으킬 수 있는 가능성이 주목받고 있습니다. 이 혁신적인 연구는 지속 가능한 건축 자재를 개발하여 지구와 우주에서의 건설 방식을 완전히 바꿀 수 있습니다.
Mycelium은 버섯의 뿌리와 같은 구조로, 건축 자재로서의 여러 가지 장점을 가지고 있습니다. NASA의 Mycotecture 프로젝트는 이러한 Mycelium의 잠재력을 극대화하여 미래의 우주 탐사와 지구상의 지속 가능한 건설에 기여하고자 합니다.
Mycelium의 소개
Mycelium은 버섯의 뿌리와 같은 균사체로 구성된 네트워크입니다. 이 균사체는 건조되면 매우 내구성이 강하고 물, 곰팡이, 화재에 저항력을 갖추게 됩니다. Mycelium은 다양한 형태로 성형될 수 있어 전통적인 건축 자재에 비해 생분해성이 뛰어난 대안이 됩니다.
또한, Mycelium은 가벼우면서도 농업 폐기물에서 재배할 수 있어 친환경적인 건축 솔루션을 제공합니다. 이러한 특성 덕분에 Mycelium은 지속 가능한 건설 자재로서의 가능성을 인정받고 있습니다.

NASA의 Mycotecture 프로젝트
NASA의 Mycotecture Off Planet 프로젝트는 달과 화성 임무를 위한 지속 가능한 거주지를 개발하는 것을 목표로 하고 있습니다. 이 프로젝트는 NASA Ames Research Center의 Lynn Rothschild가 이끌고 있으며, NASA의 혁신적 고급 개념 프로그램(NIAC)을 통해 자금을 지원받고 있습니다.
Mycotecture 프로젝트는 가벼운 구조물에 휴면 상태의 균류를 포함시켜 물을 추가하면 완전한 구조물로 성장할 수 있는 기술을 개발하고 있습니다. 또한, 방사선 보호를 강화하기 위해 멜라닌을 생산하는 균류를 통합하고, 장기간의 우주 임무에 필수적인 자가 수리 및 자가 복제 기능을 갖추고 있습니다.
이 프로젝트는 산소와 영양소를 생산하는 청록색 세균과 통합하여 3층 돔 구조를 설계하고 있습니다.

지구에서의 Mycelium 응용
Mycelium 기반 자재는 생분해성, 낮은 에너지 소비, 뛰어난 내화성과 단열 특성 등 여러 가지 장점을 가지고 있습니다. 이러한 친환경 대안은 건축 외장재, 단열재, 포장재, 가구, 심지어 섬유 등 다양한 응용 분야에서 사용될 수 있습니다.
Mycelium의 다재다능함 덕분에 혁신적인 건축 디자인과 지속 가능한 건설 솔루션이 가능해졌습니다. 일부 기업들은 이미 Mycelium의 잠재력을 탐구하고 있으며, IKEA와 Dell은 포장재로서 스티로폼의 대안으로 사용하고 있습니다.
또한, Myco-board와 같은 Mycelium 복합재는 MDF의 안전한 대안으로, 포름알데히드 방출로 인한 건강 위험을 제거합니다.

도전과 미래 전망
Mycelium 기반 자재는 광범위한 채택에 있어 몇 가지 도전에 직면해 있습니다. Mycelium 벽돌의 압축 강도는 30 psi로, 콘크리트의 4000 psi에 비해 상당히 낮아 하중을 지탱하는 구조물로 사용하기에는 제한적입니다. 또한, 응용 분야 전반에 걸쳐 일관된 품질과 구조적 안정성을 달성하는 것도 과제입니다.
그러나 지속적인 연구를 통해 이러한 자재를 보다 널리 사용할 수 있도록 개선하고 표준화하려는 노력이 계속되고 있습니다. 미래 전망으로는 상업용 우주 정거장에의 통합 가능성과 CLPS 임무를 통한 달 표면 테스트가 포함됩니다. 기술이 발전함에 따라 Mycelium은 우주와 지구에서 지속 가능한 건설 방식을 혁신할 수 있는 잠재력을 가지고 있습니다.

결론
NASA의 Mycotecture 프로젝트와 Mycelium 기반 자재는 지속 가능한 건설 솔루션을 제공하여 지구와 우주에서의 건설 방식을 혁신할 수 있는 잠재력을 가지고 있습니다. Mycelium의 생분해성, 낮은 에너지 소비, 뛰어난 내화성과 단열 특성 등은 친환경 건축 자재로서의 가능성을 보여줍니다. 이러한 혁신적인 연구와 기술 개발이 계속됨에 따라, Mycelium은 미래의 건설 혁명을 이끌어 갈 중요한 요소가 될 것입니다.
#Mycelium #NASA #Mycotecture #지속가능한건설 #친환경건축 #우주건설 #건축혁명 #생분해성자재 #혁신적기술 #미래건설
'잡식(잡다한지식)' 카테고리의 다른 글
테슬라 배터리 전기 기차: 지속 가능한 교통 혁신의 시작 (0) | 2024.08.12 |
---|---|
혁신적인 박막 태양광 기술 초박형 유연 태양전지와 페로브스카이트 탠덤 기술 (0) | 2024.08.10 |
달에서 발견된 그래핀: 우주 탐사의 새로운 장을 열다 (0) | 2024.08.09 |
Nxylon: 물질 과학에 혁명을 일으키는 우연한 발견 (0) | 2024.08.09 |
비너스에서 발견된 암모니아와 포스핀: 생명체의 가능성? (0) | 2024.08.07 |